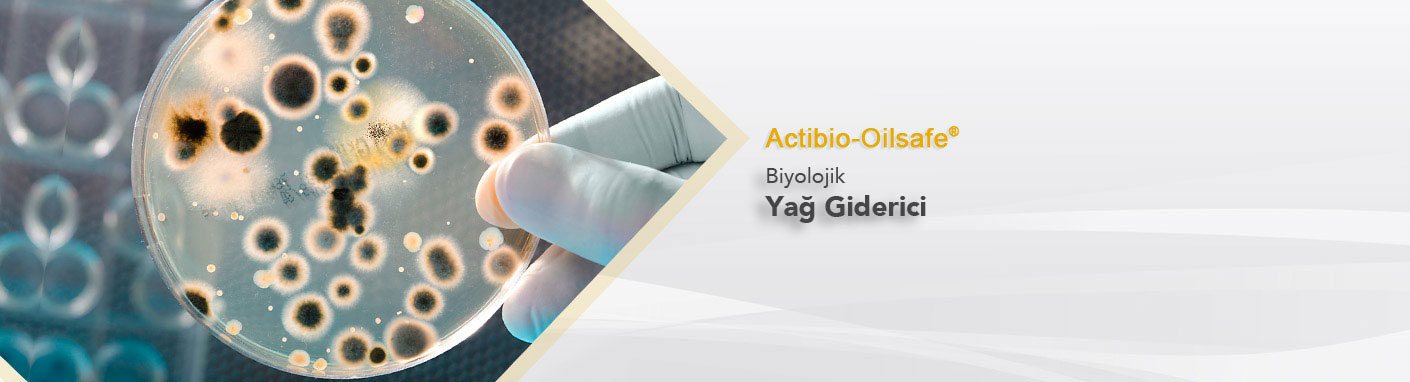
Biyolojik Yağ Giderici

Actibio® Arıtma Bakterisi
Doğal hayat ve çevremiz ancak sağlıklı bir çevre yönetimi ile korunabilir.
Gelişen teknoloji ile birlikte mikrobiyoloji üzerine araştırmalar bize mikroorganizmaların inovatif kullanımı ile çok ileri verimde prosesler geliştirmemizi sağlıyor.
Bugün dünyanın birçok yerinde yüzlerce bilim adamı çevre kirlililiğinin kontrolünde mikroorganizmaların kullanımı alanında umut veren araştırmalar yapmaktadır.
Türkiyede bu alanda araştırmalar yapmak ve dünyadaki yenilikleri en uygun şekilde ülkemizde de kullanımını sağlamayı amaçlayan firmamız AR-GE ve ÜR-GE yatırımları ile global firma olma misyonu ile çalışmaktadır.
Arıtma bakterisi üretimi alanında faaliyet gösteren firmamız ülkemizde ve yurtdışında pek çok uygulama firması ile partner olarak çalışmaktadır.
Arıtma Bakterisi kullanım alanları:
* Atıksu arıtma tesislerinde verim artırma bakterisi olarak
* Paket arıtma devreye alma bakterisi olarak
* Endüstriyel arıtma tesislerinde endüstriyel uygulama bakterisi olarak
* Atıksu arıtma tesislerinin giriş yapılarında yağ giderim bakterisi olarak
* Farklı endüstriyel ve gıda uygulamalarında atık yağ giderimi bakterisi olarak
* Mutfak hatlarında atıkyağ kaynaklı sorunların çözümü için
* Foseptik kaynaklı koku giderim bakterisi olarak
* Foseptik hatlarında tıkanmalara karşı
Kullanılabilir.